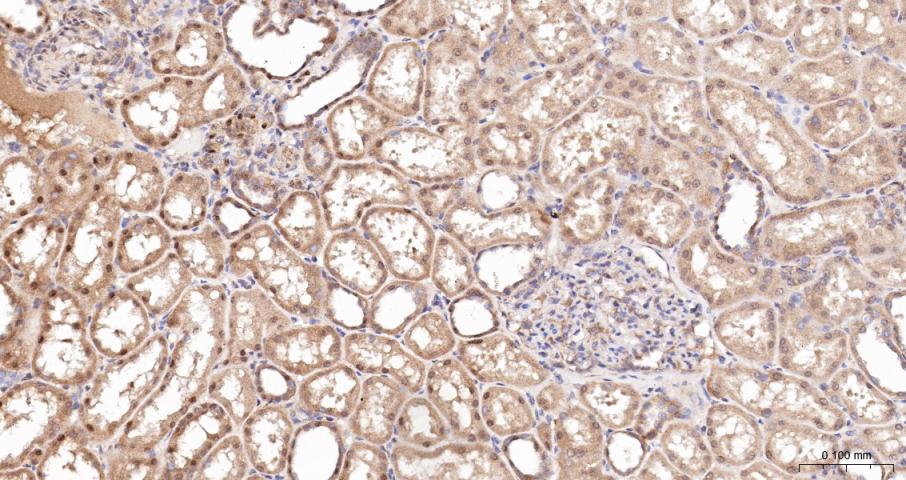
产品细节图片3
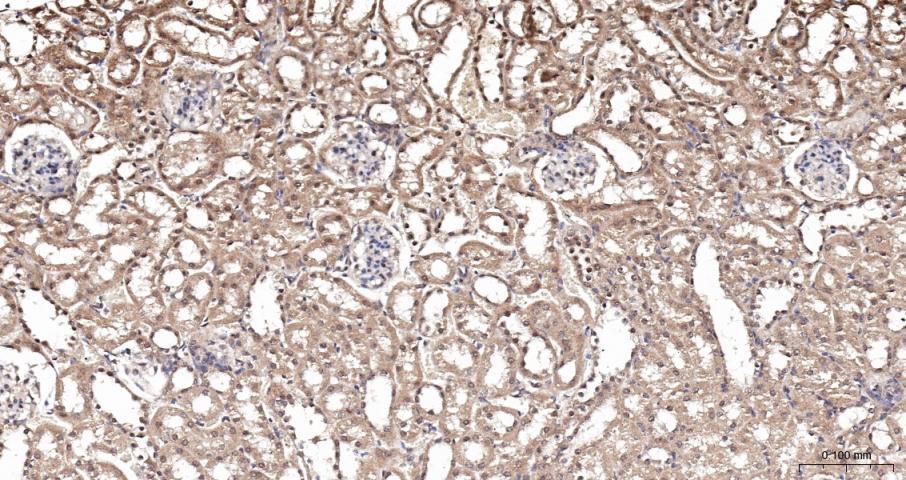
产品细节图片4

相关产品推荐更多 >
万千商家帮你免费找货
0 人在求购买到急需产品
- 详细信息
- 文献和实验
- 技术资料
- 应用范围:
产品信息以Bioss网站为准
- 规格:
50ul/100ul/200ul
| 规格: | 50ul | 产品价格: | ¥1180.0 |
|---|---|---|---|
| 规格: | 100ul | 产品价格: | ¥1980.0 |
| 规格: | 200ul | 产品价格: | ¥2800.0 |
| 产品编号 | bs-1380R |
| 英文名称 | GPR30 Rabbit pAb |
| 中文名称 | G蛋白偶联受体30抗体 |
| 英文别名 | G Protein Coupled Receptor 30; G-protein coupled receptor 30; G-protein coupled estrogen receptor 1; Membrane estrogen receptor; mER; Chemokine receptor-like 2; IL8-related receptor DRY12; Flow-induced endothelial G-protein coupled receptor 1; FEG-1; Lymphocyte-derived G-protein coupled receptor; LYGPR; GPCR-BR; CEPR; CMKRL2; DRY12; GPER. |
| 产品应用 | WB=1:500-2000, IHC-P=1:100-500, IHC-F=1:100-500, IF=1:100-500, Flow-Cyt=1μg/Test Not yet tested in other applications. |
| 交叉反应 | Human, Mouse, Rat |
| 抗体来源 | Rabbit |
| 免疫原 | KLH conjugated synthetic peptide derived from human GPR30 |
| 亚型 | IgG |
| 性状 | Liquid |
| 纯化方法 | affinity purified by Protein A |
| 克隆类型 | Polyclonal |
| 理论分子量 | 42 kDa |
| 浓度 | 1mg/ml |
| 储存液 | 0.01M TBS (pH7.4) with 1% BSA, 0.02% Proclin300 and 50% Glycerol. |
| 研究领域 | Epigenetics and Nuclear Signaling > Nuclear Signaling Pathways > Nuclear Receptors > Estrogen Metabolism > Pathways and Processes > Endocrine metabolism > Hormone biosynthesis Metabolism > Pathways and Processes > Metabolic signaling pathways > Energy transfer pathways > Energy Metabolism Neuroscience > Neurotransmission > Receptors / Channels > GPCR > More GPCR Signal Transduction > Signaling Pathway > G Protein Signaling > GPCR |
| 亚细胞定位 | Cell membrane; Multi-pass membrane protein. Endoplasmic reticulum membrane; Multi-pass membrane protein (By similarity). Golgi apparatus membrane; Multi-pass membrane protein (By similarity). Note=Protein has been detected in the cell membrane, endoplasmic reticulum and Golgi apparatus. It is currently unclear whether this is a cell surface or intracellular receptor. |
| 组织特异性 | Ubiquitously expressed, but is most abundant in placenta. In brain regions, expressed as a 2.8 kb transcript in basal forebrain, frontal cortex, thalamus, hippocampus, caudate and putamen. |
| 相似性 | Belongs to the G-protein coupled receptor 1 family. |
| 功能 | Receptor for estrogen. |
| 保存条件 | Shipped at 4℃. Store at -20℃ for one year. Avoid repeated freeze/thaw cycles. |
| 注意事项 | This product as supplied is intended for research use only, not for use in human, therapeutic or diagnostic applications. |
| 背景资料 | This gene is a member of the G-protein coupled receptor 1 family and encodes a multi-pass membrane protein that localizes to the endoplasmic reticulum. The protein binds estrogen, resulting in intracellular calcium mobilization and synthesis of phosphatidylinositol 3,4,5-trisphosphate in the nucleus. This protein therefore plays a role in the rapid nongenomic signaling events widely observed following stimulation of cells and tissues with estrogen. Alternate transcriptional splice variants which encode the same protein have been characterized. [provided by RefSeq, Jul 2008] |
| 应用 | 推荐稀释比例 |
| {WB} | {1:500-2000} |
| {IHC-P} | {1:100-500} |
| {IHC-F} | {1:100-500} |
| {IF} | {1:100-500} |
| {Flow-Cyt} | {1μg/Test} |

Primary Antibody (green line): Rabbit Anti-PR30 antibody (bs-1380R),Dilution: 1μg /10^6 cells;
Isotype Control Antibody (orange line): Rabbit IgG .
Secondary Antibody (white blue line): Goat anti-rabbit IgG-FITC,Dilution: 1μg /test.
风险提示:丁香通仅作为第三方平台,为商家信息发布提供平台空间。用户咨询产品时请注意保护个人信息及财产安全,合理判断,谨慎选购商品,商家和用户对交易行为负责。对于医疗器械类产品,请先查证核实企业经营资质和医疗器械产品注册证情况。
文献和实验[IF={{ 7.129 }}] {Qianfeng Liu. et al. Perfluoroalkyl substances promote breast cancer progression via ERα and GPER mediated PI3K/Akt and MAPK/Erk signaling pathways. ECOTOX ENVIRON SAFE. 2023 Jun;258:114980} {WB} {Human}
[IF={{ 5.6 }}] {Zihao Fang. et al. 17β-Estradiol mediates TGFBR3/Smad2/3 signaling to attenuate the fibrosis of TGF-β1-induced bovine endometrial epithelial cells via GPER. J CELL PHYSIOL. 2023 Nov;:} {WB,IHC} {Bovine}
[IF={{ 4.8 }}] {Lixia Chen. et al. Activation of GPER1 by G1 prevents PTSD-like behaviors in mice: Illustrating the mechanisms from BDNF/TrkB to mitochondria and synaptic connection. CNS NEUROSCI THER. 2024 Jul;30(7):e14855} {WB} {Mouse}
[IF={{ 4.057 }}] {Pei H et al. G Protein-Coupled Estrogen Receptor 1 Inhibits Angiotensin II-Induced Cardiomyocyte Hypertrophy via the Regulation of PI3K-Akt-mTOR Signalling and Autophagy. International Journal of Biological Sciences,2018 15(1), 81–92.} {ICC} {Rat}
[IF={{ 4 }}] {Hanfei Wang. et al. Mapping the 5-HTergic neural pathways in perimenopausal mice and elucidating the role of oestrogen receptors in 5-HT neurotransmission. HELIYON. 2024 Mar;10:e27976} {WB} {Mouse}
david9931 请问各位大侠,有没有订做过磷酸化的丝氨酸或磷酸化的苏氨酸抗体,哪家公司做的比较好,小弟想订做目的蛋白特异位点的丝氨酸、苏氨酸的磷酸化的抗体,帮忙给指点下,多谢啦 euthor_hsu 这种抗体定做很难。毕竟要的是抗一个特异的氨基酸的磷酸化位点。 就我所知cisbio有anti-phosphothronine 和anti-phosphotyrosine的抗体,PAb和MAb都有,但是没有anti
= NAL), appears to form upon oxidative cyclization of the nonfluorescent 2:1 lysine-HNE Michael adduct-Schiff base cross-link (Scheme 1). Polyclonal antibody (PAb) to the NAL-HNE fluorophore was raised in rabbit and found to be highly specific
。 (三) 试剂 1. 洗涤缓冲液:0.01mol/L pH7.4磷酸缓冲液(PBS),含0.05%Tween-0;2. RAMIG溶液,或“激素-蛋白”复合物;3. 0.1%封闭蛋白(该蛋白应不同于免疫原中的载体蛋白);4. 抗激素Mab,或Pab;5. 激素标准品母液,及参比系列溶液(按双倍或四倍系列稀释);6. HRP标记激素,或HRP-GARIG;7. 邻苯二胺(OPD)基质液:5mgOPD溶于12.5ml0.01mol/L pH5.0PBS,用前加入30%H
技术资料暂无技术资料 索取技术资料










